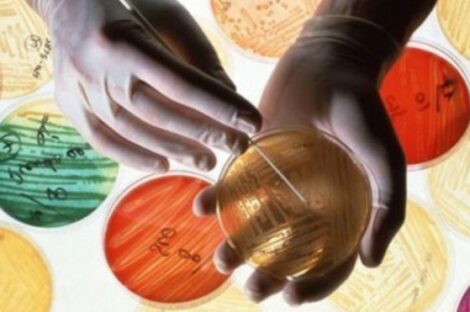

المتحدث باسم عملية الكرامة يُعلن إنشقاقه عن خليفة حفتر
وكالة ليبيا الرقمية أعلن المتحدث باسم قوات عملية الكرامة محمد الحجازي انشقاقه وعدد من أمراء وقادة المحاور عن قائده خليفة...

وكالة ليبيا الرقمية أعلن المتحدث باسم قوات عملية الكرامة محمد الحجازي انشقاقه وعدد من أمراء وقادة المحاور عن قائده خليفة...

وكالات أكدت مصادر سورية أن الوفد الحكومي السوري إلى جنيف سيكون برئاسة المندوب السوري في الأمم المتحدة بشار الجعفري،...

وكالة ليبيا الرقمية أكد مصدر مطلع في مرادة استشهاد الشبان الثلاثة العاملين في حراسة الشركة التركية شمال المدينة، بعد...

وكالات وجدت دراسة حديثة أن تقديرات كميات الأسماك التي تم صيدها خلال الأعوام الستين الماضية أقل من الكميات الحقيقية...

وكالات يشكل عدم انتظام ضربات القلب خطرا أكبر على صحة النساء منها على صحة الرجال، حسب بحث علمي حديث...

وكالات اكتُشف أكبر عدد أولي في جامعة ميسوري بالولايات المتحدة الأمريكية، عن طريق جهاز كمبيوتر. والأعداد الأولية، مثل اثنان،...

وكالات نشر علماء الأرصاد في الولايات المتحدة والمملكة المتحدة بيانات تشير إلى أن عام 2015 كان الأدفأ في تاريخ...

وكالة ليبيا الرقمية قال عميد بلدية طبرق الناجي مازق في تصريح خاص أمس الأربعاء في تصريح صحفي “أستغرب ما تناقلته...

وكالات “يييهاااو!” صيحات أطلقها مهندس الصواريخ وهو يقود بصعوبة شاحنة صالحة لكل التضاريس فوق صخور وقفار صحراء نيفادا. هو...
وكالات طالبت أكثر من 80 شركة أدوية الحكومات بابتكار طرق جديدة لتمويل أبحاث تطوير المضادات الحيوية. ونشرت الشركات بيانا...

وكالات خلص تحقيق بريطاني إلى أن مقتل الجاسوس الروسي السابق ألكسندر ليتفينينكو ربما كان بموافقة الرئيس الروسي فلاديمير بوتين....

وكالة ليبيا الرقمية قام عميد بلدية زليتن المهندس مفتاح الطاهر حمادي رفقة عضو المجلس الأعلي للدولة الدكتور عبدالله جوان،...

وكالات اذا كان روما يبحث عن حافز لتجاوز سلسلة نتائجه المخيبة في آخر شهرين فعليه أن يقارن نفسه بيوفنتوس...

وكالات يفترض الا يواجه الصربي نوفاك ديوكوفيتش والأمريكية سيرينا وليامز صعوبة في الوصول للدور الرابع عند استئناف مشوار الدفاع...
[daily_salat_times]
